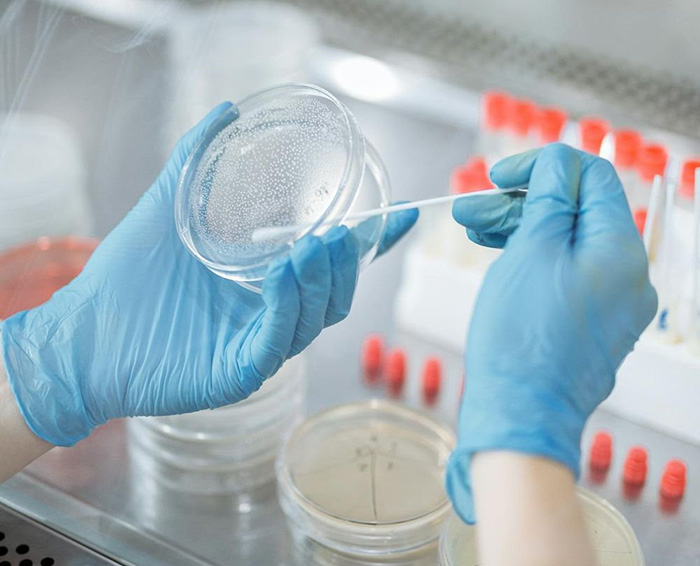

Авторов: 57 639
On-line – 31 079Зрителей: 6200
Авторов: 24879
Загружено работ – 2 197 139
Новости
Как полиция несколько лет охотилась за несуществующей маньячкой: Тайна призрака Хайльбронна


В 2007 году в немецком городе Хайльбронн произошло ужасное преступление. На парковке среди бела дня, расстреляли двух сотрудников полиции. Напарники Мишель Кизеветтер и Мартин Арнольд заехали туда перекусить. Полчаса спустя таксист сообщил в полицию о том, что обнаружил их застреленными прямо в машине. На месте преступления были найдены следы ДНК, не принадлежавшие жертвам. Эту же ДНК до этого обнаруживали десятки раз на месте подобных преступлений. Она принадлежала женщине, но ни одна камера ни разу не зафиксировала её. Женщину-маньяка окрестили «Призраком Хайльбронна»...
Жестокое преступление
После сообщения таксиста о преступлении, на место прибыли правоохранители. То, что они увидели — 22-летняя Мишель Кизеветтер и её напарник Мартин Арнольд. Оба имели огнестрельное ранение в голову, но Мишель была мертва, а Мартин ещё дышал. Он выжил, но на всю жизнь остался инвалидом.

Уникальная ДНК
Оперативники осмотрели машину. Табельное оружие и наручники обоих полицейских отсутствовали. Однако эксперты-криминалисты обнаружили важную улику — следы ДНК внутри автомобиля, не принадлежавшие ни одной из жертв. Поиск по базе данных показал, что ДНК совпадает с ДНК неопознанной женщины, уже разыскиваемой в связи с более чем сорока преступлениями, включая убийства, ограбления и похищения людей, совершёнными в Германии, Австрии и даже во Франции.
Впервые эту ДНК обнаружили на месте преступления в далёком 1993 году. Пенсионерку и церковную старосту Лизелотту Шленгер задушили в её собственной квартире шнурком, которым был перевязан букет цветов. Никаких отпечатков пальцев тогда не нашли, свидетелей тоже не было, а вот незнакомый генетический материал был обнаружен.

Чуть менее 10 лет спустя, эту же ДНК обнаружили на месте другого преступления. На этот раз имело место тоже удушение, только садовой верёвкой. Опять не было больше никаких улик и свидетелей. Судебные эксперты определили, что генетический материал принадлежал женщине, вероятно, восточноевропейского происхождения.
Спустя всего несколько месяцев, таинственный ДНК-профиль вновь всплыл. Правда, на этот раз обстановка не имела отношения к убийству. Маленький мальчик гулял у дома и подобрал на тротуаре весьма любопытную для себя вещицу, которой никогда до этого не видел. Ценную находку он принёс домой и гордо продемонстрировал резко побледневшей матери. Неудивительно, ведь ребёнок принёс в дом использованный шприц. Испуганная женщина схватила сына в охапку и вместе с его находкой отвезла в больницу, где доктора сделали тест на ВИЧ.
Как появился «Призрак Хайльбронна»
К огромному облегчению матери, никакого ВИЧ не было, а вот ДНК, как оказалось, принадлежит жестокому убийце. У следователей начала выстраиваться довольно стройная версия: некая неопознанная женщина с зависимостью, скорее всего бездомная, скитается по Германии и убивает всех без разбора, вероятно, из-за очередной дозы. СМИ охотно подхватили эту теорию. Она начала обрастать всё большим количеством подробностей и предположений. Психиатры настаивали, что у женщины, возможно, было тяжёлое детство. Она, наверное, росла в приёмной семье и подвергалась насилию. Образ травмированной, непредсказуемой и жестокой женщины, бродяги, употребляющей запрещённые вещества, быстро укоренился в общественном сознании.
В последующие годы ДНК загадочной женщины продолжала появляться на местах преступлений по всей Германии, Австрии и даже Франции. Её обнаружили на недоеденном печенье, брошенном рядом с местом ограбления дома на колёсах в Буденхайме (Германия); на игрушечном пистолете, оставленном после кражи драгоценных камней в Арбуа (Франция) в 2004 году; и на месте ограбления магазина оптики в Гальнойкирхене (Австрия).

В Саарбрюккене (Германия) камень, которым разбили окно во время взлома в 2006 году, содержал следы её ДНК. Та же ДНК была обнаружена в руинах заброшенного общественного бассейна после кражи со взломом, а также в ходе многочисленных других взломов и вторжений в дома по всей Центральной Европе. Никакой закономерности, никакой логики, никакого единого образа действий. Единственным, что связывало между собой все эти преступления - была ДНК одной и той же женщины. К концу 2000-х годов эта неопознанная подозреваемая была связана почти с 40 преступлениями, как тяжкими, так и мелкими.
Полиция окрестила неизвестную подозреваемую «Женщиной без лица». Но после убийства офицера полиции Мишель Кизеветтер, которое было больше похоже на казнь, она получила другое прозвище - «Призрак Хайльбронна». Пресса начала писать о женщине-маньяке, которая умело заметает следы и всегда ускользает от правосудия, совершая преступления по всей Европе.
Тупик
Все силы полиции были брошены на поиски серийной убийцы. За её голову была назначена огромная награда в несколько сотен тысяч евро. При этом никто не мог ответить на вопросы о том: почему никто и никогда не видел эту женщину, как ей удаётся орудовать на столь обширной территории и при этом ни одна камера наблюдения ни разу её не зафиксировала? Несостыковок становилось всё больше, а ДНК фантома продолжала появляться на различных местах преступлений.
В 2009 году расследование и вовсе зашло в тупик. При исследовании обгоревшего тела мужчины, просителя убежища во Франции, криминалисты снова обнаружили ДНК «Призрак Хайльбронна». Но на этот раз её присутствию не было никакого логического объяснения. Обстоятельства заставили следователей серьёзно пересмотреть свои собственные процедуры.

Ужасная правда
Более подробное изучение процесса сбора улик выявило правду: ватные палочки, использованные для сбора образцов ДНК на нескольких местах преступлений, были загрязнены ещё до того, как попали к следователям. Эти палочки, изготовленные австрийским поставщиком медицинских товаров, содержали следы ДНК работницы фабрики. Так называемый и уже столь разрекламированный «Призрак Хайльбронна» на самом деле никогда не существовал.
Как оказалось впоследствии, ватные палочки с одного и того же завода, имеющие следы ДНК работницы, использовали многие полицейские управления. Эксперты были уверены в их стерильности, так как данный завод имел несокрушимую репутацию. Открытие повергло в состояние шока всех сотрудников правоохранительных органов. Это было унизительно и сокрушительно — годы следствия впустую. Всё это время они гонялись за призраком в прямом смысле этого слова. Самое обидное, что этот фантом отвлёк внимание следователей от реальных зацепок. Например, дело об убийстве офицера Мишель Кизеветтер до сих пор не раскрыто.

Этот вопиющий инцидент выявил критические недостатки в судебно-медицинском протоколе и привёл к масштабным реформам в области работы с уликами. После этого изменились стандарты и требования к производству расходных материалов. Ужесточился контроль, чтобы избежать присутствия человеческой ДНК на материалах, предназначенных для сбора биологических улик на месте преступления.
Также дело «Призрака Хайльбронна» продемонстрировало ненадёжность данных судебной экспертизы. Анализ ДНК всегда казался идеальным инструментом для идентификации следов. Следователи поняли, что доказательства, казавшиеся всегда железобетонными, далеко не всегда указывают на истинную личность преступника. Иногда они даже мешают увидеть реальную картину произошедшего. Судьи получили веские основания не допускать вынесения обвинительных приговоров исключительно на основе косвенных улик ДНК. Так одна ошибка смогла изменить в корне всю судебную систему Европы.
Источник: https://kulturologia.ru/blogs/280825/65263/
Комментарии:
Нет комментариев Трибуна сайта
Трибуна сайта Наш рупор
Наш рупор Радио & Чат
Радио & Чат





 Категории
Категории Работы на продажу
Работы на продажу